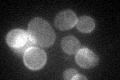
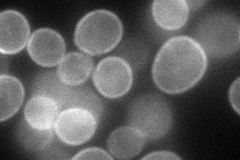
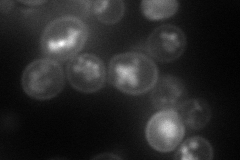
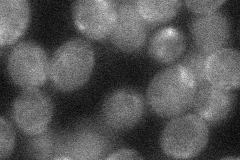
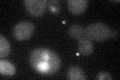

View description
Plasma membrane ATP-binding cassette (ABC) transporter, multidrug transporter mediates export of many different organic anions including oligomycin; similar to human cystic fibrosis transmembrane receptor (CFTR)
Localization:
Intensity:
Fold change:
Significance:
-
C’ GFP library in SD
cell periphery32.72 -
N' NOP1pr-GFP in SD
cell periphery80.9159 -
N' TEF2pr-mCherry in SD
cell periphery,vacuole74.4337 -
N' NATIVEpr-GFP in SD

cell periphery31.611 -
N' TEF2pr-VC and Cyto-VN in SD
below threshold28.5839 -
C’ GFP library in SD+DTT

cell periphery39.581.2No -
C’ GFP library in SD+H2O2

cell periphery37.521.14No -
C’ GFP library in Starvation Media

cell periphery26.180.79No -
C’ GFP library on the background of Pup2-DaMP
cytosol -
C’ GFP library on the background of CCT mutant

cell periphery23.8590.728854No
